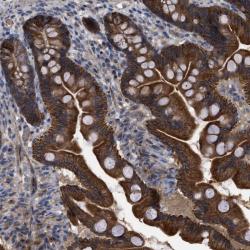

Antibody data
- Antibody Data
- Antigen structure
- References [3]
- Comments [0]
- Validations
- Western blot [1]
- Immunohistochemistry [1]
Submit
Validation data
Reference
Comment
Report error
- Product number
- sc-83 - Provider product page

- Provider
- Santa Cruz Biotechnology
- Proper citation
- Santa Cruz Biotechnology Cat#sc-83, RRID:AB_2202299
- Product name
- Anti-TGFB3
- Antibody type
- Polyclonal (Antigen purified)
- Antigen
- Synthetic peptide
- Reactivity
- Human
- Host
- Rabbit
Submitted references Five-year rehospitalization outcomes in a cohort of patients with acute ischemic stroke: medicare linkage study.
Revealing the high-energy electronic excitations underlying the onset of high-temperature superconductivity in cuprates
Linkage of body build with sex, eye color, and freckling.
Lakshminarayan K, Schissel C, Anderson DC, Vazquez G, Jacobs DR Jr, Ezzeddine M, Luepker RV, Virnig BA
Stroke; a journal of cerebral circulation 2011 Jun;42(6):1556-62
Stroke; a journal of cerebral circulation 2011 Jun;42(6):1556-62
Revealing the high-energy electronic excitations underlying the onset of high-temperature superconductivity in cuprates
Claudio Giannetti, Federico Cilento, Stefano Dal Conte, Giacomo Coslovich, Gabriele Ferrini, Hajo Molegraaf, Markus Raichle, Ruixing Liang, Hiroshi Eisaki, Martin Greven, Andrea Damascelli, Dirk van der Marel, Fulvio Parmigiani
Nature Communications 2011 Jun;2():353-
Nature Communications 2011 Jun;2():353-
Linkage of body build with sex, eye color, and freckling.
BRUES AM
American journal of human genetics 1950 Sep;2(3):215-39
American journal of human genetics 1950 Sep;2(3):215-39
No comments: Submit comment
Supportive validation
- Submitted by
- per
- Main image

- Experimental details
- Western blot analysis of antibody specificity using a routine panel composed of IgG/HSA-depleted human plasma and protein lysates from selected human tissues and cell lines.
- Validation comment
- Band of predicted size in kDa (+/-20%) with additional bands present.
- Primary Ab dilution
- 1:500
- Secondary Ab dilution
- 1:3000
- Lane 1
- Marker [kDa]: 250, 130, 95, 72, 55, 36, 28, 17, 11
- Lane 2
- RT-4
- Lane 3
- U-251MG sp
- Lane 4
- Human Plasma
- Lane 5
- Liver
- Lane 6
- Tonsil
- Theoretical target weight
- [kDa] 47
Supportive validation
- Submitted by
- per
- Main image
- Experimental details
- Immunohistochemical staining of human small intestine shows strong cytoplasmic and membranous positivity in glandular cells.
- Validation comment
- Staining pattern partly consistent with experimental and/or bioinformatic data.